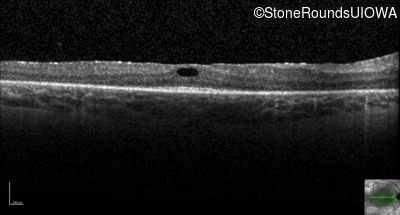
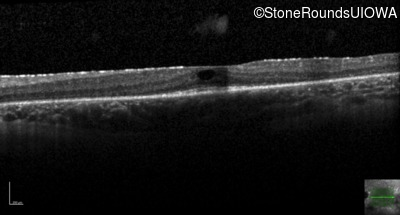

Case
SR428
Student Mode
Type 2 Usher Syndrome (IB1b)
Female
Female
Hidden
SR428
Student Mode
Type 2 Usher Syndrome (IB1b)
Female
Female
Diagnosis & molecular findings
| Disease | Gene | Allele 1 variant(s) | Allele 2 variant(s) | Inheritance mode |
|---|---|---|---|---|
| Type 2 Usher Syndrome | USH2A | Cys536Arg TGC>CGC | Trp3521Arg TGG>CGG | AR |
Disease:
Gene:
Allele 1:
Cys536Arg TGC>CGC
Allele 2:
Trp3521Arg TGG>CGG
Inheritance:
AR